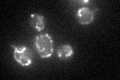
YDR204W
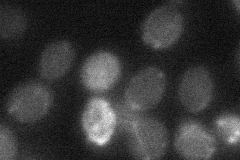
YDR204W

View description
Protein with a role in ubiquinone (Coenzyme Q) biosynthesis, possibly functioning in stabilization of Coq7p; located on the matrix face of the mitochondrial inner membrane; component of a mitochondrial ubiquinone-synthesizing complex
Localization:
Intensity:
Fold change:
Significance:
-
C’ GFP library in SD
mitochondria31.98 -
N' NOP1pr-GFP in SD

mitochondria133.99 -
N' TEF2pr-mCherry in SD

punctate,mitochondria12.2176 -
N' NATIVEpr-GFP in SD
below threshold22.8585 -
N' TEF2pr-VC and Cyto-VN in SD

#N/A0 -
C’ GFP library in SD+DTT

mitochondria28.320.88No -
C’ GFP library in SD+H2O2

mitochondria28.40.88No -
C’ GFP library in Starvation Media

mitochondria46.181.44Yes -
C’ GFP library on the background of Pup2-DaMP

mitochondria -
C’ GFP library on the background of CCT mutant

mitochondria34.49671.07837No
